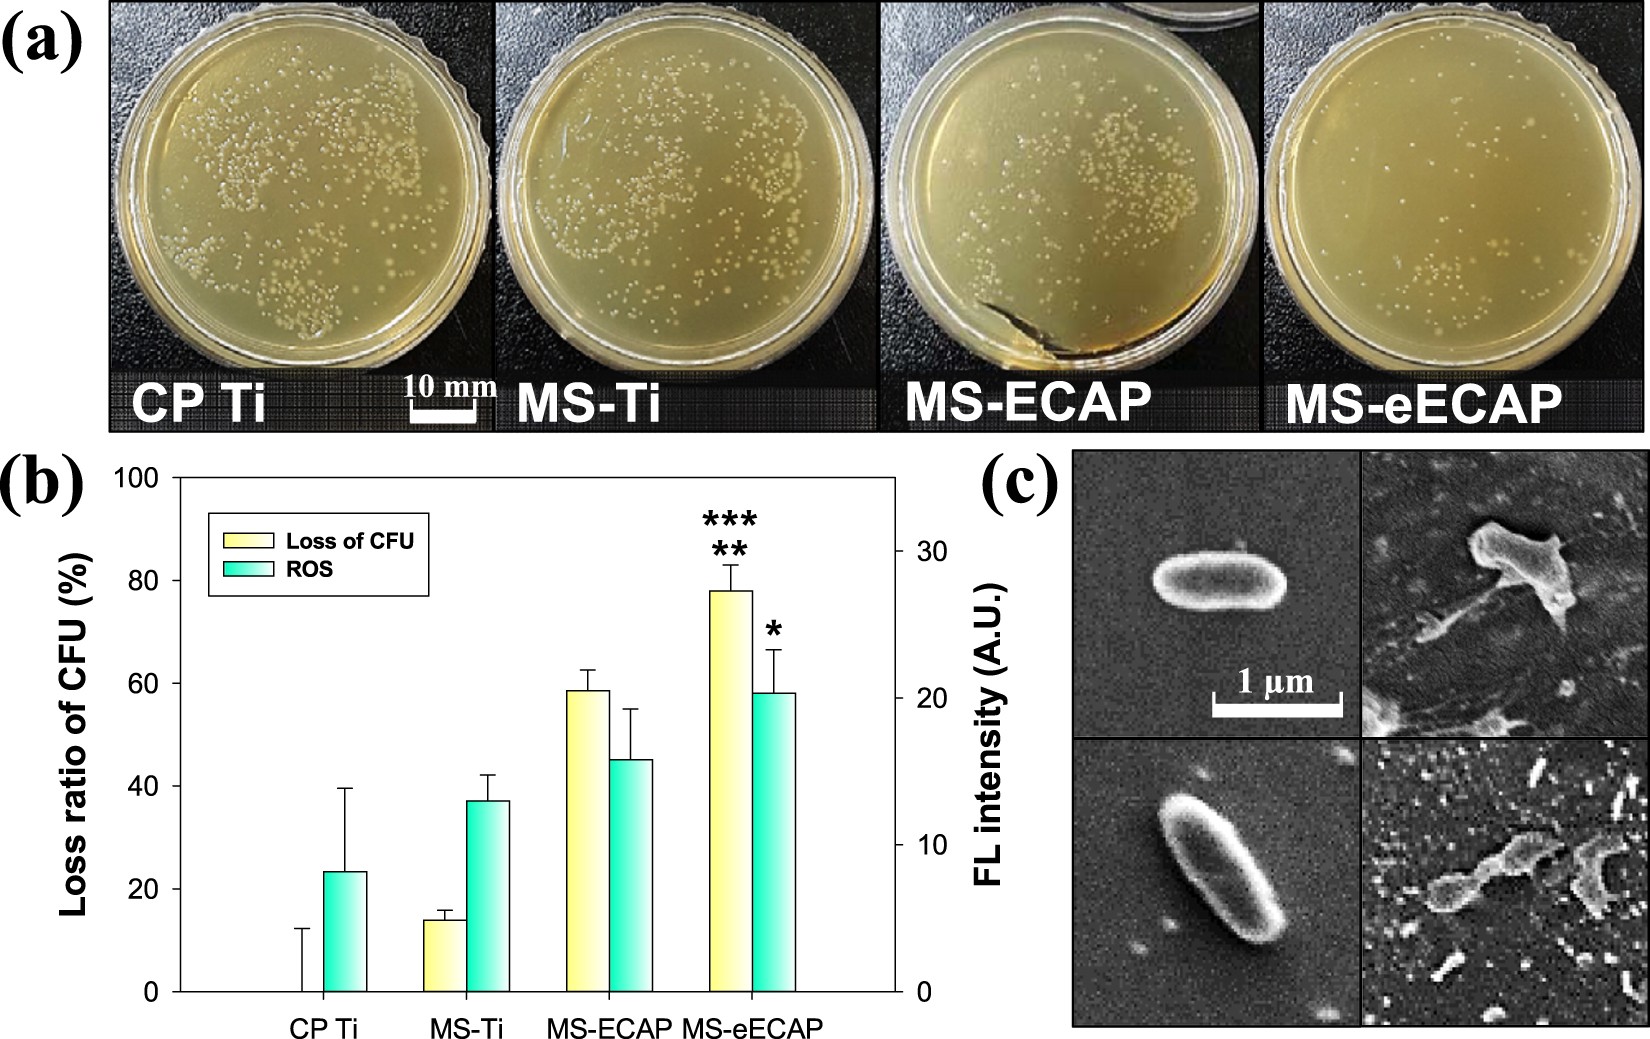
Figure 5

Figure 5
Antibacterial activity of MoS2 coated specimens. (a) Photographs of E. coli growth on bacterial culture medium (overnight incubation at 37 °C) and (b) bacterial growth inhibition rate of each substrate at 37 °C for 6 h. ***p < 0.001 and *p < 0.05 compared to the CP Ti substrates; and **p < 0.01 compare with the MS-Ti substrate. (c) SEM images of E. coli exposed to the CP Ti and the MS-eECAP substrates at 37 °C for 6 h. The left and right side images are E. coli of the surface of the CP Ti and the MS-eECAP, respectively.